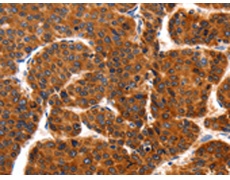
一抗

|
Background: |
HSP90 proteins are highly conserved molecular chaperones that have key roles in signal transduction, protein folding, protein degradation, and morphologic evolution. HSP90 proteins normally associate with other cochaperones and play important roles in folding newly synthesized proteins or stabilizing and refolding denatured proteins after stress. TRAP1 is a mitochondrial HSP90 protein. Other HSP90 proteins are found in cytosol and endoplasmic reticulum |
|
Applications: |
ELISA, WB, IHC |
|
Name of antibody: |
TRAP1 |
|
Immunogen: |
Fusion protein of human TRAP1 |
|
Full name: |
TNF receptor-associated protein 1 |
|
Synonyms: |
HSP75, HSP90L |
|
SwissProt: |
Q12931 |
|
ELISA Recommended dilution: |
2000-10000 |
|
IHC positive control: |
Human liver cancer and human esophagus cancer |
|
IHC Recommend dilution: |
100-200 |
|
WB Predicted band size: |
80 kDa |
|
WB Positive control: |
Mouse kidney tissue, 293T and hela cells |
|
WB Recommended dilution: |
1000-5000 |


 購(gòu)物車
購(gòu)物車 幫助
幫助
 021-54845833/15800441009
021-54845833/15800441009